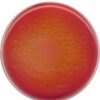

(R)-(-)-Menthyl acetate for synthesis 10ml Merck
0 ₫
(R)-(-)-Menthyl acetate for synthesis code 8161470010. Hóa chất dùng làm thuốc thử trong tổng hợp các hợp chất hữu cơ và tổng hợp các sản phẩm cho dược phẩm. Sử dụng rộng rãi trong phòng thí nghiệm trường học, viện nghiên cứu,… Quy cách: chai thủy tinh 10ml.
| Tên sản phẩm: | (R)-(-)-Menthyl acetate for synthesis |
| CTHH: | C₁₂H₂₂O₂ |
| Code: | 8161470010 |
| Cas: | 2623-23-6 |
| Hàm lượng: | ≥ 97.0 % |
| Hãng – Xuất xứ: | Merck – Đức |
| Ứng dụng: | – Hóa chất dùng làm thuốc thử trong tổng hợp các hợp chất hữu cơ và tổng hợp các sản phẩm cho dược phẩm. Sử dụng rộng rãi trong phòng thí nghiệm trường học, viện nghiên cứu,… |
| Tính chất: |
– Hình thể: lỏng – Khối lượng mol: 198.3 g/mol – Mật độ: 0,925 g/cm3 |
| Bảo quản: | Lưu trữ dưới + 30 °C. |
| Quy cách: | chai thủy tinh 10ml |
Thông tin đặt hàng:
| Code | Quy cách |
| 8161470010 | Chai thủy tinh 10ml |
| 8161470100 | Chai thủy tinh 100ml |
Hãy là người đầu tiên nhận xét “(R)-(-)-Menthyl acetate for synthesis 10ml Merck” Hủy
Sản phẩm tương tự
Hóa chất thí nghiệm
Dung dịch hiệu chuẩn Natri 2.3 g/l chai 500 mL HI7080L Hanna
Hóa chất thí nghiệm
Hóa chất thí nghiệm
Hóa chất thí nghiệm
Potassium iodate solution for 1000 ml, c(KIO₃) = 1/₆₀ mol/l (0.1 N) Titrisol®
Hóa chất thí nghiệm
Hóa chất thí nghiệm
CAL Check™ Chuẩn Mangan Thang Thấp, 0 và 150 μg/L HI96748-11 Hanna
Hóa chất thí nghiệm
Hóa chất thí nghiệm
CAL Check™ chuẩn Amoni thang trung, 0.0 và 6.0 mg/L HI96715-11 Hanna

Đánh giá
Chưa có đánh giá nào.